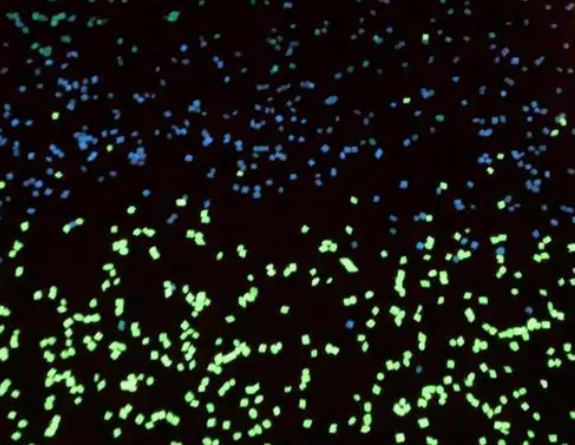

FITC-Dextran 葡聚糖-异硫氰基荧光素 dex-FITC 荧光标记葡聚糖
发布时间:2023-06-07     作者:axc   分享到:
FITC-Dextran 葡聚糖-异硫氰基荧光素 dex-FITC 荧光标记葡聚糖
中文名称:异葡聚糖-异硫氰基荧光素
英文名称:FITC-Dextran
纯度:95%+
存储条件:-20°C,避光,避湿
外观:固体或粘性液体,
性状:基于不同的分子量,呈白色/类白色固体,或粘稠液体。
溶剂:二氯甲烷,DMSO,水等常规有机溶剂。
稳定性:冷藏保存,避免反复冻融。
分子量(PEG ):2000、3400、5000,其他分子量可以定制。
为确保产品的稳定性,请注意在恒温干燥以后才能打开包装取用
FITC(异硫氰酸荧光素)是一种荧光素衍生物。常作为荧光探针应用于制备分子生物学或糖类聚合物的结合物分子,例如葡聚糖、壳聚糖、活性基团等。FITC常用作蛋白质或多糖的不同底物的标记试剂,以及标记抗体(IgG)以及其它免疫应用。
相关产品:
DSPE-PEG3.4K-Mal DSPE-PEG修饰马来酰亚胺
DSPE-PEG3.4K-DBCO 二硬脂酰基磷脂酰乙醇胺偶联PEG二苯基环辛炔
DSPE-PEG3.4K-APOE 二硬脂酰基磷脂酰乙醇胺改性PEG载脂蛋白E
DSPE-PEG3.4K 二硬脂酰基磷脂酰乙醇胺修饰聚乙二醇
DSPE-PEG2K-细辛醚 DSPE-PEG修饰细辛醚
温馨提醒:仅供科研,不能用于人体实验axc.2023.06
用途:科研
状态:固体/粉末/溶液
产地:西安
保存:冷藏




齐岳微信公众号
官方微信
库存查询